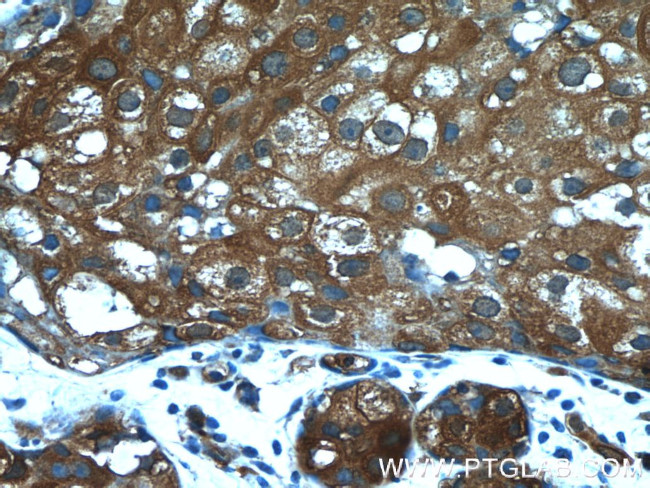
PKLR Antibody in Immunohistochemistry (Paraffin) (IHC (P))

Search
Proteintech
PKLR Polyclonal Antibody
{{$productOrderCtrl.translations['antibody.pdp.commerceCard.promotion.promotions']}}
{{$productOrderCtrl.translations['antibody.pdp.commerceCard.promotion.viewpromo']}}
{{$productOrderCtrl.translations['antibody.pdp.commerceCard.promotion.promocode']}}: {{promo.promoCode}} {{promo.promoTitle}} {{promo.promoDescription}}. {{$productOrderCtrl.translations['antibody.pdp.commerceCard.promotion.learnmore']}}
产品信息
22456-1-AP
种属反应
已发表种属
宿主/亚型
分类
类型
抗原
偶联物
形式
浓度
规格
纯化类型
保存液
内含物
保存条件
运输条件
产品详细信息
Immunogen sequence: PLSRDPTEV TAIGAVEAAF KCCAAAIIVL TTTGRSAQLL SRYRPRAAVI AVTRSAQAAR QVHLCRGVFP LLYREPPEAI WADDVDRRVQ FGIESGKLRG FLRVGDLVIV VT (446-556 aa encoded by BC025737)
靶标信息
The protein encoded by this gene is a pyruvate kinase that catalyzes the transphosphorylation of phohsphoenolpyruvate into pyruvate and ATP, which is the rate-limiting step of glycolysis. Defects in this enzyme, due to gene mutations or genetic variations, are the common cause of chronic hereditary nonspherocytic hemolytic anemia (CNSHA or HNSHA). Multiple transcript variants encoding different isoforms have been found for this gene.
仅用于科研。不用于诊断过程。未经明确授权不得转售。
生物信息学
蛋白别名: isozymes R/L; L-PK; Pyruvate kinase 1; pyruvate kinase isozyme R/L; Pyruvate kinase isozymes L/R; pyruvate kinase isozymes R/L; Pyruvate kinase PKLR; pyruvate kinase type L; pyruvate kinase, liver and blood cell; pyruvate kinase, liver and RBC; pyruvate kinase, liver and red blood cell; R-type/L-type pyruvate kinase; Red cell/liver pyruvate kinase; unnamed protein product
基因别名: CNSHA2; Pk-1; PK1; PKL; Pklg; PKLR; PKRL; R-PK; RPK
UniProt ID: (Human) P30613, (Rat) P12928
Entrez Gene ID: (Human) 5313, (Mouse) 18770, (Rat) 24651